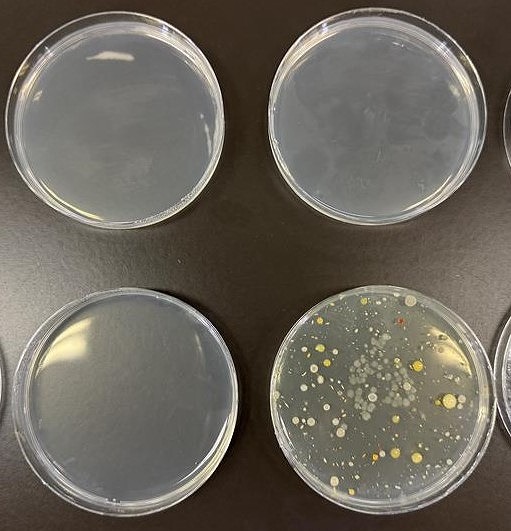
2025水⑩

皆さんこんにちは!
商品開発もできる管理栄養士を目指す!相愛大学管理栄養学科のブログを見に来てくださりありがとうございます。
今回は2回生後期の食品衛生学実験の授業を紹介します。
食品衛生学実験は、食品の安全性を確保するための検査である食品衛生検査の
微生物検査、食品添加物試験、理化学試験の代表的な項目を実施し学習します。
今回は上水道、下水道、飲料水等水について勉強しました。
飲用の適否を判断する検査には基礎的性状、細菌学的検査、理化学的検査があります。
今回は、
基礎的性状から、pH値
細菌学的検査から、一般細菌
理化学的検査から、アンモニア性窒素、亜硝酸性窒素、残留塩素、総硬度
を実験しました。
試料は、水道水、超硬水ミネラルウォーター、アンモニアと亜硝酸性窒素を加えて作成した水、ビオトープの水を使用しました。
pH値はpH試験紙にて測定します。


アンモニア性窒素、亜硝酸性窒素、残留塩素、総硬度はマイクロピペットを使用し、
試料を検査薬が入ったチューブに入れて良く振って色調表と比較して濃度を判定します。






一般細菌は、培地を作成し培養します。

35℃24時間培養したものがこちらです。
右下のシャーレにはいろいろな菌がいるのがわかりますね。
学生は実験結果から飲用の適否を考察し、
その後先生から、どこで採取した水なのか発表されました。
超硬水ミネラルウォーターを飲んだことが無い学生が多くいたので試飲しました。
口に入れるとのど越しや味等で軟水と硬水の違いを感じていました。
管理栄養学科のブログでは、いろいろな授業の紹介をしていますので、
また管理栄養学科のブログ見に来てください!
助手 福井